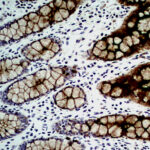

|
|---|
 Anti-Carbonic Anhydrase IX Anti-Carbonic Anhydrase IXBuy here |
 Anti-Carcinoembryonic Antigen (CEA) Anti-Carcinoembryonic Antigen (CEA)Buy here |
 Anti-Carcinoembryonic Antigen (CEA) Anti-Carcinoembryonic Antigen (CEA)Buy here |
 Anti-Carcinoembryonic Antigen (CEA) Anti-Carcinoembryonic Antigen (CEA)Buy here |
 Anti-Caspase-3 p17 Anti-Caspase-3 p17Buy here |
 Anti-Caspase-3, Clone 31A1067 Anti-Caspase-3, Clone 31A1067Buy here |
 Anti-Catenin Delta 1 (P120) Anti-Catenin Delta 1 (P120)Buy here |
 Anti-Cathepsin D Anti-Cathepsin DBuy here |
 Anti-Cathepsin D Anti-Cathepsin DBuy here |
 Anti-Cathepsin K(CTSK/2791) Anti-Cathepsin K(CTSK/2791)Buy here |